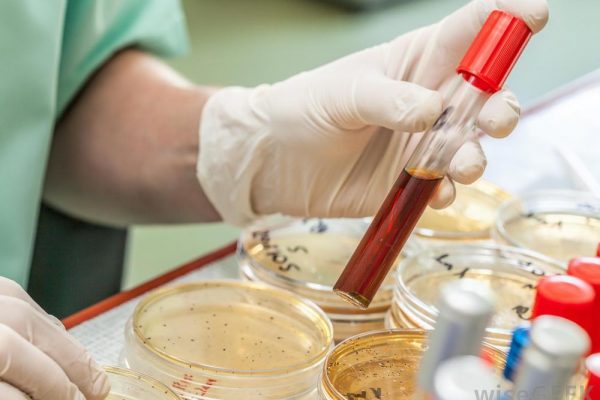
22

What we offer
Tri-County Testing is a renowned Collection Site for all your testing needs. We are committed to increasing workplace safety, which is why our testing is quick, efficient, and reliable. We cater to a range of testing and offer in-house compliance to customers we use Quest Diagnostics,LabCorp,Alere,CRL,MedTox, to ensure the viability of tests and data